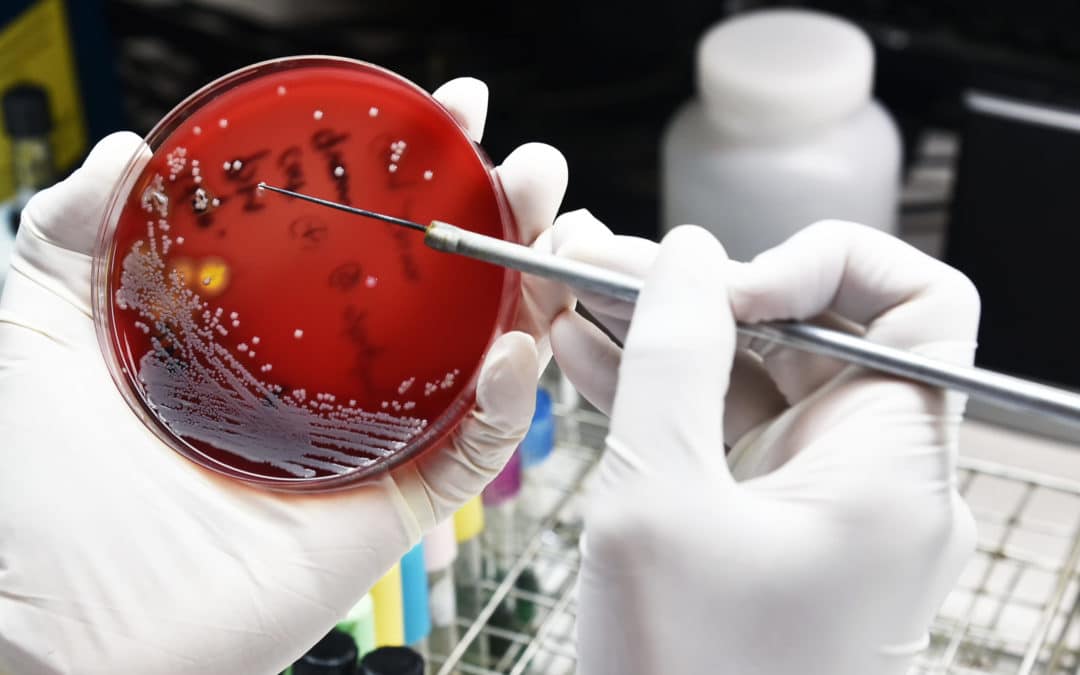
The European Commission is failing to preserve vital antibiotics for human health

by European Public Health Alliance | Jun 30, 2022 | Opinion
Guest article Jaume Vidal, Senior Policy Advisor at Health Action International (HAI) In October 2020 in the midst of the COVID-19 pandemic, South Africa and India submitted a proposal to waiver certain dispositions of the Trade- Related aspects of Intellectual...

by European Public Health Alliance | Jun 30, 2022 | Opinion
Guest article by Ancel·la Santos, Senior Health Policy Officer, The European Consumer Organisation (BEUC) To ensure recovery when facing health issues and a better quality of life among European citizens, it is essential that people get timely access to medicines and...

by European Public Health Alliance | Jun 30, 2022 | Opinion
Guest article by Charlotte Roffiaen, European Policy Advisor at France Assos Santé For many years, the increasing prices of innovative medicines have focused the attention of the European public health community. Affordability issues were threatening both patient...

by European Public Health Alliance | Jun 30, 2022 | Opinion
Article by Julia Aube, Policy Trainee for Healthcare Delivery The COVID-19 pandemic has jeopardised the access and availability of medicines in the EU, therefore, making the EU more resilient regarding the supply of pharmaceuticals is a key objective of...

by European Public Health Alliance | Jun 28, 2022 | Opinion
Things go viral, again With the COVID-19 pandemic still alive and kicking, a monkeypox outbreak “goes viral” in high-income countries, and in a matter of days transitions from an “exotic disease that happens to others” into a household name. In a matter of...

by European Public Health Alliance | May 31, 2022 | Opinion
Guest article by Calum MacKichan & Sarah de Maaker – Standing Committee of European Doctors (CPME) The problem of antimicrobial resistance (AMR) is faced by doctors across Europe on a daily basis who are unable to successfully treat patients who have...